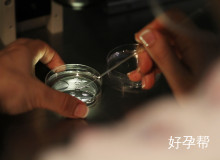
上海试管婴儿费用可以分期吗？2025最新费用明细与分期方案解析

第 1 5 5 5 9 期
上海试管婴儿费用可以分期吗?2025最新费用明细与分期方案解析
发布:2025-09-26 10:52:06
导语
准备进行试管婴儿治疗的家庭最关心的问题莫过于费用能否分期。小编走访上海多家生殖中心发现,近40%的医疗机构已推出分期方案。本文将为您详细解读2025年上海试管婴儿费用构成与分期政策,助您科学规划生育开支。
好孕百科 / undefined / 上海试管婴儿费用可以分期吗?2025最新费用明细与分期方案解析

导语
准备进行试管婴儿治疗的家庭最关心的问题莫过于费用能否分期。小编走访上海多家生殖中心发现,近40%的医疗机构已推出分期方案。本文将为您详细解读2025年上海试管婴儿费用构成与分期政策,助您科学规划生育开支。
上海试管婴儿费用可以分期吗?2025最新费用明细与分期方案解析
导语
准备进行试管婴儿治疗的家庭最关心的问题莫过于费用能否分期。小编走访上海多家生殖中心发现,近40%的医疗机构已推出分期方案。本文将为您详细解读2025年上海试管婴儿费用构成与分期政策,助您科学规划生育开支。

一、2025年上海试管婴儿费用全解析
基础检查项目包括激素六项、输卵管造影等,建议提前做好检查规划。促排卵药物根据个体差异分进口与国产,某三甲医院数据显示,35岁以下患者平均用药成本比高龄患者低42%。手术费用包含取卵、胚胎培养等核心环节,部分机构提供阶梯式收费方案。
二、分期付款具体实施方案
| 机构类型 | 分期期数 | 首付比例 |
|---|---|---|
| 公立三甲 | 3-6期 | 30%起 |
| 私立专科 | 6-12期 | 15%起 |
需提供近6个月银行流水、社保缴纳证明等材料。某私立机构推出『阶段性付款』模式,根据治疗进度分阶段结算费用。
三、费用控制实用技巧
2025年起,染色体筛查等5类项目纳入医保报销范围。建议选择包含胚胎冷冻的套餐,某生殖中心统计显示套餐用户平均节省18%开支。特别注意分期合同中关于中断治疗的条款细则,保留好所有付款凭证。
四、真实分期案例参考
张女士夫妇选择12期分期完成三代试管治疗,通过合理规划将月均支出控制在工资收入的20%以内。某公立医院患者通过分期+医保报销组合,总费用节省近2万元。遇到方案调整时,及时与医院财务部门沟通变更分期协议。
结语
针对上海试管婴儿费用可以分期吗这个问题,2025年各大医疗机构已形成成熟解决方案。建议夫妻双方根据自身经济状况,选择正规机构的分期方案。提前了解费用构成与优惠政策,配合专业指导,能让生育之路走得更顺畅。

-
认真对待备孕工作才有回报
 各位姐妹们,我今天去官宣好孕啦来,说下自己的备孕经历吧。我今年25,结婚两年,平时工作比较忙碌,也总是想着自己还年轻,就把怀孕计划暂缓了。然而周围的朋友们,都纷纷怀孕了,自己突然觉醒到,我可能要努力备
各位姐妹们,我今天去官宣好孕啦来,说下自己的备孕经历吧。我今年25,结婚两年,平时工作比较忙碌,也总是想着自己还年轻,就把怀孕计划暂缓了。然而周围的朋友们,都纷纷怀孕了,自己突然觉醒到,我可能要努力备 -
吃中药调理身体后怀上的
 我内膜就薄,还有子宫内膜异位,排卵内膜不同步,卵泡发育不良,严重宫寒等等问题我都有,因为一直没有怀上,心理压力也不断的增大,特别是身体大问题没有,小问题不断的情况下,更甚,都要抑郁症了,后来听说中药可
我内膜就薄,还有子宫内膜异位,排卵内膜不同步,卵泡发育不良,严重宫寒等等问题我都有,因为一直没有怀上,心理压力也不断的增大,特别是身体大问题没有,小问题不断的情况下,更甚,都要抑郁症了,后来听说中药可 -
分享我第一胎的备孕经历
 在备孕圈混了四年,看着大家都纷纷当妈妈,心里真的很嫉妒!自己也经常测然后自己欺骗自己着床晚,最后等来的都是大姨妈,说说我的身体情况:1.月经间期出血。每个月到排卵那几天,就会开始有血,一直持续到来月经
在备孕圈混了四年,看着大家都纷纷当妈妈,心里真的很嫉妒!自己也经常测然后自己欺骗自己着床晚,最后等来的都是大姨妈,说说我的身体情况:1.月经间期出血。每个月到排卵那几天,就会开始有血,一直持续到来月经





















